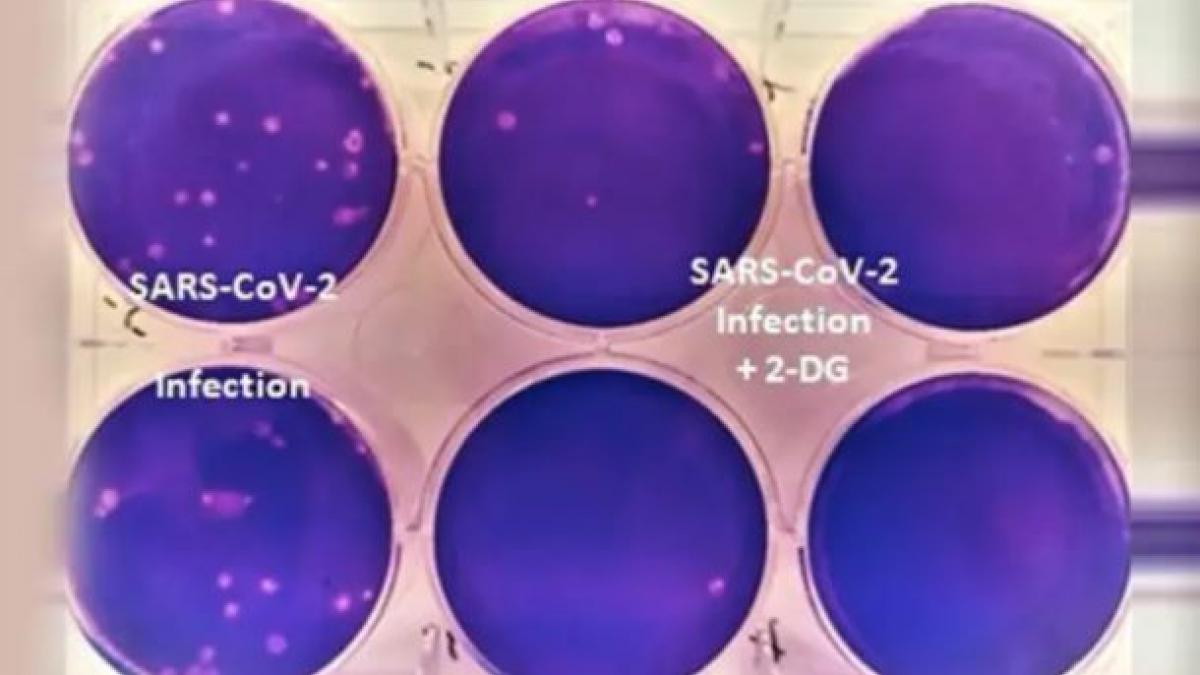
DRDO's anti-Covid drug 2-DG

DRDO की Corona दवा 2DG की कीमत हुई तय, देखें कितने में मिलेगा एक पाउच
DRDO की Corona दवा 2DG की कीमत हुई तय, देखें कितने में मिलेगा एक पाउच
कोरोना महामारी के इलाज के लिए बनाई गई DRDO की 2DG दवा की कीमत तय हो गई है. 2DG के एक पाउच की कीमत 990 रुपए रखी गई है. केंद्र और राज्य सरकारों के साथ ही सरकारी अस्पतालों को इसकी खरीद पर छूट दी जाएगी. शुरुआती ट्रायल में पता चला था कि इससे मरीज के ऑक्सीजन लेवल में भी सुधार होता है. देखें आजतक संवाददाता मंजीत नेगी की ये रिपोर्ट.